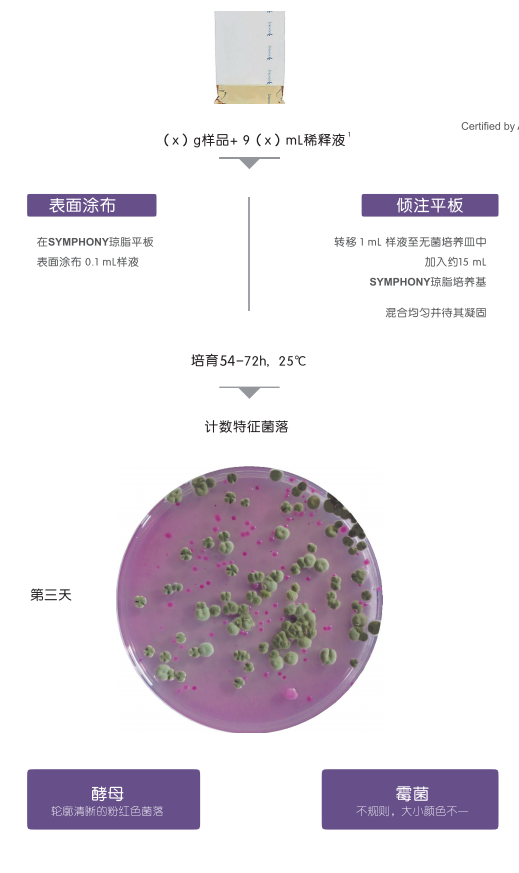

Symphony 琼脂:
Symphony 琼脂可对所有人类和动物食品中的酵母菌和霉菌进行计数,与其水活性无关。也可用于生产区域环境样品的控制。对于水样,可使用该培养基通过膜过滤进行分析 。SYMPHONY琼脂经NF验证,可用于在参考编号BKR 23/11-12/18下对所有人类和动物食品中的酵母菌和霉菌进行计数。该方法允许在54小时后进行计数,而不是使用标准方法的5天。
订购信息:
脱水培养基:
BK227HA-500g 小瓶
待熔化基础培养基:
BM19108-10瓶 200mL/瓶